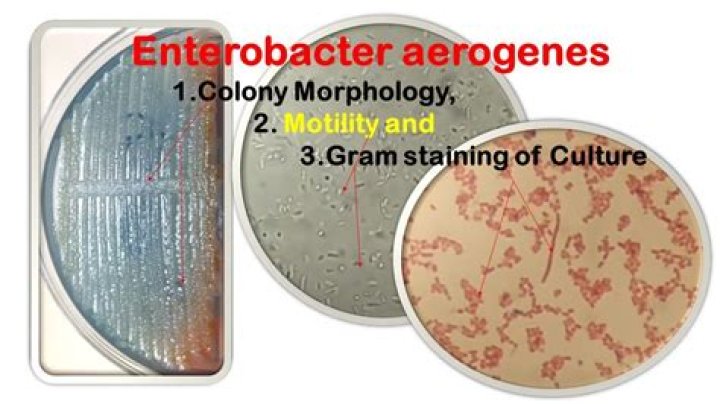

Duros are a Latino snack made of wheat flour and look a bit like a very hard pasta. The traditional shape is a rectangle with grooves but wagon wheel shapes are common too. Typically the duros are deep fried but they can also be microwaved.
What does duros taste like?
I expected the cracker to taste salty like a chicharron, but it was actually rather light and airy. It felt good to eat in a wholesome way, easy on my belly. I picked up the whole thing and ate it like a slice of pizza, and then decided to snap it and break off smaller pieces. A little messy, but it worked.
What are duros for?
Duritos Wheels Wheat Snacks for frying. Flour pellets to make flour chicharrones. A pasta pellet product called "duritos", made from wheat flour. Before cooking, they are hard, orange in color, and look like little pinwheels.
What goes on duros?
Duros- 1 Mexican duro.
- 2 oz of cabbage.
- 1/4 white onion fillet.
- 2 tablespoons of refried beans.
- 3 oz of cueritos on vinegar.
- Rajas of jalapeno peppers.
- 1 lemon.
- 2 oz. Sour cream.
What are fried duros?
Chicharrones de harina (also known as duros de harina) are the addictive, crunchy wheat chips in the ever-adorable wheel shapes, doused in lime juice and generously sprinkled with tongue-tingling spice mix. ... Fry a few at a time in the hot oil until they puff up to twice their size and become crisp.
DUROS Wheat Puff Cinnamon Twists with Rotini Pasta | TIKTOKS CINNAMON TWISTS
23 related questions foundIs duros vegetarian?
Modeled after (and often referred to as) chicharrónes (or fried pork skins), these crunchy, wheat-based wheels are airy, light, and completely vegan. How to prepare: Uncooked duros are hard, quarter-sized, orange wagon wheels often stored in bulk bins alongside beans and other dried goods in many Latin supermarkets.
What is a chilindrina food?
For the uninitiated, a chilindrina consists of a flour fritter that serves as a bed for heaps of lettuce, chopped tomato, cucumber, pickled pig skin bits and avocado (so it's healthy), all doused with Valentina sauce and mayo.
Where are duros from?
The Duros were a humanoid species native to Duro, a planet located in the Duro sector of the galaxy's Core Worlds. They had smooth blue-green skin, red eyes, lipless mouths, and long thin noseless faces with green blood.
Can you cook duros in the microwave?
These are my new favorite treat any time of day. Just try to tear that paper bag out of the grasp! Supposedly, you can also cook the duros in the microwave with no water or oil by placing a few of the pasta wheels on a paper towel and microwaving for 30 - 35 seconds until they puff up into cute and crunchy doo-dads.
Does Walmart sell duros?
Fiesta Round Duros, 4 oz - Walmart.com.
Are duros made of pork?
Depending on language and region, duros may also be called durros, duritos, or pasta para duros. Although many people believe they are a form of pork rind, they are actually made of flour.
What are Mexican Doritos?
Chicharrones de Harina are also labeled Duros, Duritos, Mexican Wagon Wheels, or Mexican Wheat Snacks. You can find them in the ethnic aisle of most grocery stores or in Mexican markets. Chicharrones will keep in a sealed plastic bag for up to a week.
What is on a Chicharron Preparado?
Chicharrón preparado, or prepared chicharrónes, are made with the large rectangular fried chicharrón de harina, which is then topped with chopped cabbage, diced tomatoes, sour cream, cotija cheese, sliced avocados, cueritos (pickled pork rind slices), and hot sauce, usually Salsa Valentina.
What are Mexican snacks?
The Ultimate Guide to Mexican Snacks- Gansitos. ...
- Banderillas. ...
- Takis. ...
- Cacahuates Japones. ...
- Duvalín. ...
- Maruchan. ...
- Pelon Pelo Rico. ...
- Vero Mango.
Are pickled pork skin cooked?
El Mexicano Pork Skins come pickled in vinegar and can be used as an appetizer or snack. Fully cooked and ready to eat.
Is chamoy mega vegan?
Chamoy! Again, make sure to check the label because each brand makes their chamoy a little different. But, for the most part, chamoy is a vegan snackers BFF.
How do you eat Chicharron de harina?
Instructions- Put your chicharrones de harina in a bowl and set aside.
- Cut key limes in half and squeeze juice directly over chicharrones. ...
- Drizzle salsa over the chicharrones to your liking and serve immediately.
- Use reserved key limes to squeeze over chicharrones closer to the bottom of the bowl and add more salsa.
Are Mexican Doritos different?
This Mexican version of Doritos has a more intense, concentrated, and distinct cheese and jalapeno flavor than our domestic version in the United States.